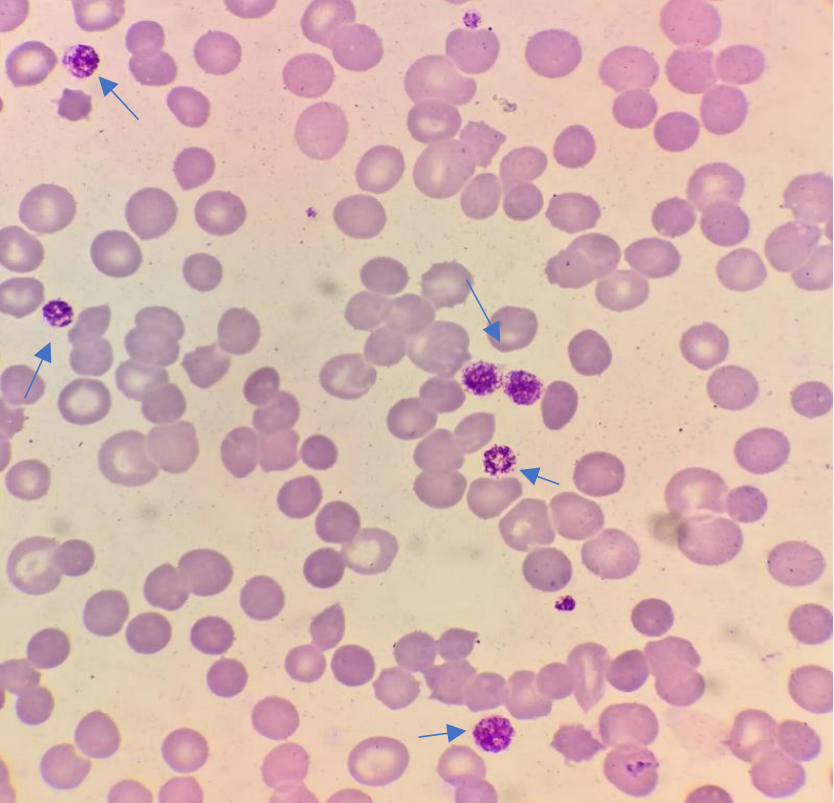

血小板平均体积分布宽度大,就说明血小板大小不均匀,大的大,小的小,差别很大,这种情况常见的疾病有免疫性血小板减少性紫癜急性髓系白血病巨幼细胞性贫血慢性粒细胞性白血病以及巨大血小板综合征另外,脾脏切除以后,以及血栓性疾病的时候,也会出现血小板平均体积分布宽度大所以,如果出现了血小板;血小板分布宽度就是反映外周血中血小板体积大小离散度的指标,也就是反应外周血中血小板大小是否均匀的参数血小板分布宽度偏低,说明外周血中的血小板大小较一致,相差不大可见于部分正常人,还可见于骨髓造血功能衰竭性疾病,最常见的就是再生障碍性贫血再生障碍性贫血时,由于造血干细胞受损伤,骨髓造血;血小板分布宽度偏高表明血小板大小差别大,可能提示存在某些疾病或造血功能异常以下是具体解释血小板分布宽度的含义PDW是反映血小板容积大小的离散度的一个指标增高表明血小板大小悬殊,即血小板之间的大小差别较大可能的疾病PDW增高可见于巨大血小板综合征血栓性疾病等这些疾病可能导致血小板形态和功能的异常,从而使得。
血小板分布宽度是反映血小板体积大小的离散度的指标其作用及相关解释如下作用评估血小板体积的一致性PDW通过测量单个血小板体积的变化系数,来评估血小板体积的一致性或离散度辅助诊断血液疾病当PDW偏高时,可能提示血小板体积大小悬殊,这有助于医生诊断某些血液疾病PDW偏高的可能原因巨幼细胞贫血;血小板分布宽度PDW是衡量血小板体积差异的一个指标当PDW升高时,说明血小板大小差异显著,可能见于巨大血小板综合征血栓性疾病等而平均血小板容积MPV则反映了单个血小板的平均体积如果MPV增加,可能意味着血小板破坏增多,但骨髓的代偿能力仍然良好当仅有血小板分布宽度偏高时,可能表明血小板大小。
血小板分布宽度又名血小板体积分布宽度,是反映血液内血小板容积变异的参数,血小板分布宽度在正常范围内,表明血小板体积均一性高,血小板分布宽度增加,提示血小板体积大小不均,个体间相差悬殊,常见于急性髓系白血病巨幼细胞性贫血慢性粒细胞性白血病脾切除巨大血小板综合征血栓性疾病等血小板分布;血小板分布宽度PDW是用来评估血小板数量和大小的指标之一在正常情况下,血小板的分布宽度很小,说明它们具有相对均匀的大小和形态但是,当血小板分布宽度偏高时,表示血小板的大小和形态存在不同程度的异常这可能意味着存在一些疾病或状况,如贫血炎症感染出血或恶性肿瘤因此,当血小板分布宽度;血小板分布宽度是反映血小板容积大小的离散度的指标以下是关于血小板分布宽度的详细解释定义血小板分布宽度用所测单个血小板容积大小的变异系数来表示,是评估血小板大小分布均匀性的一个重要参数PDW减少的意义当PDW减少时,表明血小板的均一性较高,这是骨髓造血功能正常的表现,通常不需要过于担心P。
首先血小板分布宽度是PDW是反映血小板容积大小的离散度PDW增高表明血小板大小悬殊,见于巨大血小板综合征血栓性疾病等平均血小板容积MPV是代表单个血小板的平均容积MPV增加见于血小板破坏增加而骨髓代偿能力良好者其次单纯血小板分布宽度偏高,可能提示血小板大小不一,一般这种情况若血常规,血小板。
转载请注明来自极限财经,本文标题:《什么是血小板分布宽度?》
京公网安备11000000000001号
京ICP备11000001号
还没有评论,来说两句吧...